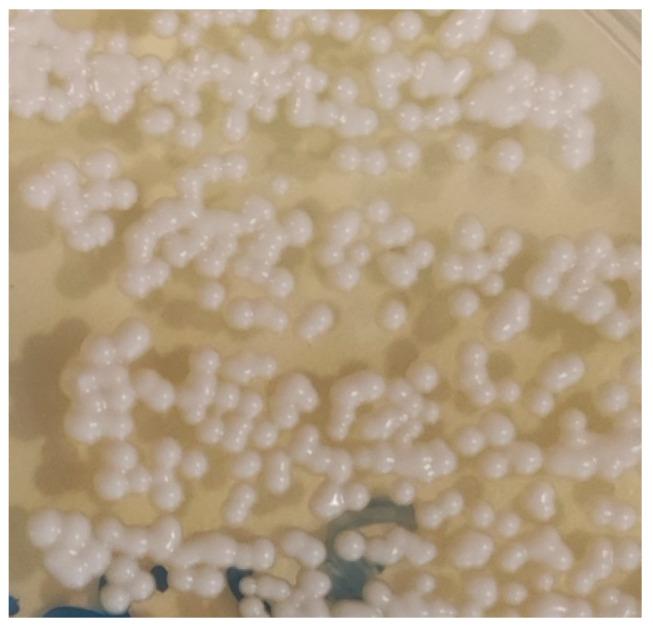

What Do We Know About spp. in Portugal? One Health Systematic Review in a Comprehensive 13-Year Retrospective Study (2013-2025).
作者信息
Lopes Ricardo, Garcês Andreia, Carvalho Hugo Lima de, Silva Vanessa, Sampaio Filipe, Fernandes Cátia, Barros Gonçalo, Brito Alexandre Sardinha de, Silva Ana Rita, Duarte Elsa Leclerc, Cardoso Luís, Coelho Ana Cláudia
机构信息
Department of Veterinary Sciences, University of Trás-os-Montes e Alto Douro (UTAD), 5000-801 Vila Real, Portugal.
Department of Veterinary and Animal Sciences, University Institute of Health Sciences (IUCS), CESPU, 4585-116 Gandra, Portugal.
出版信息
J Fungi (Basel). 2025 Sep 12;11(9):672. doi: 10.3390/jof11090672.
Cryptococcosis, caused by the and species complexes (pathogenic spp.), is an environmentally acquired mycosis of One Health relevance. This study integrates a PRISMA-compliant systematic review (2000-2025) of Portuguese animal, human, and environmental reports with a 13-year retrospective dataset of laboratory-confirmed veterinary cryptococcosis cases (2013-2025). Clinical specimens were cultured and identified by MALDI-TOF mass spectrometry, and associations were assessed using χ and Fisher's exact tests. Of 1059 submissions, 48 (4.5%) were culture-positive: 6.8% of canine, 5.3% of feline samples, and 4.0% of avian samples, with no detections in other vertebrate groups ( = 0.705). predominated in carnivores (73.7%), while (formerly was most frequent in birds (86.2%). Infection was not associated with sex or age. Seasonality was evident, with a July peak and summer predominance ( = 0.010). Most cases were from the Centre region (62.5%), with significant regional variation of spp. distribution ( < 0.001). The systematic review confirmed autochthonous complex disease and widespread contamination in pigeon guano and arboreal niches. These findings demonstrate a compartmentalised eco-epidemiology, reinforcing the need for integrated molecular typing, antifungal susceptibility testing, and coordinated human-animal-environment surveillance to inform targeted prevention and control strategies in Portugal.